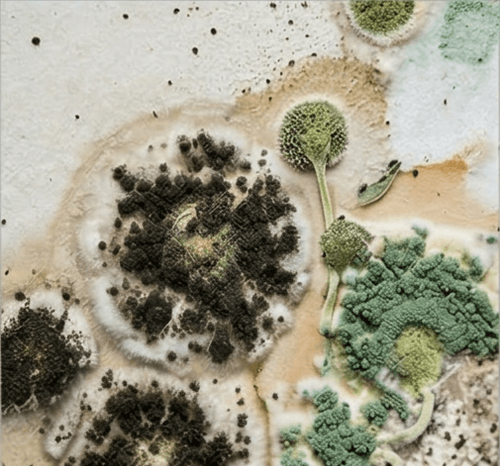
Mold

Pest Encyclopedia

Ants
Medium dangerMonomorium pharaonis / Lasius niger
Pharaoh ants are tiny, indoor-dwelling insects that build multi-queen colonies, making them extremely difficult to eradicate with over-the-counter sprays. They contaminate food and carry pathogens.

Fleas
Medium dangerCtenocephalides
Fleas are jumping parasites that feed on the blood of pets and humans. In urban areas, basement fleas can invade first-floor apartments through cracks and ventilation.

Flies
Medium dangerMuscidae
Synanthropic flies breed in decaying organic matter and carry serious pathogens, posing a massive risk to food safety and public health.

Ticks
High dangerIxodidae
Ixodid ticks are blood-feeding arachnids prevalent in tall grass and wooded areas across Belarus. They become active in early spring.
Mold
Medium dangerFungi
Mold is a fungus that thrives in damp, poorly ventilated environments. Its spores are highly toxic and can cause asthma, severe allergies, and respiratory issues.

Pigeons
Low dangerColumba livia
Urban pigeons cause severe property damage with their highly acidic droppings and act as vectors for diseases like ornithosis and histoplasmosis.

Bed bugs
High dangerCimex lectularius
Bed bugs are nocturnal parasites that feed on human blood. They hide in mattresses, bed frames, and baseboards. Bites typically appear in a linear pattern on the skin.

Carpet beetles
Low dangerDermestidae
Carpet beetles are small insects whose larvae feed on animal-based materials like wool, fur, and leather. They can cause severe damage to household items.

Moths
Low dangerTineola bisselliella / Plodia interpunctella
Moths cause significant damage to fabrics and stored food products. The larvae are responsible for the destruction, feeding on natural fibers or dry goods like flour and grains.

Mice
Medium dangerMus musculus
The house mouse is a highly adaptable rodent that invades homes and businesses, especially during the colder months. They carry diseases and can cause electrical fires by chewing on wires.

Wasps
Medium dangerVespidae
Wasps and hornets are aggressive flying insects that build nests under roofs, in attics, and in trees. Their stings are highly painful and can trigger severe allergic reactions or anaphylactic shock.

Mosquitoes
Low dangerCulicidae
Mosquitoes require stagnant water to breed. Their bites cause severe itching and allergic reactions, ruining outdoor activities during the summer months.

Cockroaches
High dangerBlattella germanica
The German cockroach is a widespread synanthropic insect in Belarus. They thrive in warm, humid indoor environments like kitchens and food processing facilities. They are mechanical vectors for diseases such as Salmonella and E. coli.

Rats
High dangerRattus norvegicus
The Brown Rat is a highly intelligent and adaptable rodent that causes severe economic damage and poses significant health risks. In Belarus, they often migrate indoors during autumn.